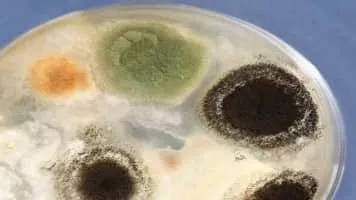

Pestalotiopsis Microspora
| Use attributes for filter ! | |
| Scientific name | Pestalotiopsis microspora |
|---|---|
| Rank | Species |
| Division | Ascomycota |
| Higher classification | Pestalotiopsis |
| Class | Sordariomycetes |
| Order | Xylariales |
| Date of Reg. | |
| Date of Upd. | |
| ID | 2274498 |
About Pestalotiopsis Microspora
Pestalotiopsis microspora is a species of endophytic fungus capable of breaking down and digesting polyurethane. Originally identified in fallen foliage of common ivy in Buenos Aires, it also causes leaf spot in Hypericum 'Hidcote' shrubs in Japan.